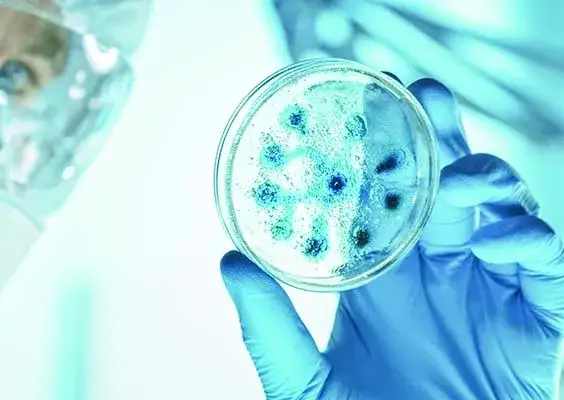
Kiedy odkryto wirusy? Kluczowe fakty i znaczenie dla nauki

Kiedy odkryto wirusy? To pytanie ma kluczowe znaczenie dla zrozumienia historii biologii i medycyny. Pierwsze odkrycie wirusów miało miejsce w 1892 roku, kiedy to rosyjski naukowiec Dmitri Iwanowski wykazał, że czynnik zakaźny choroby mozaikowej tytoniu potrafił przejść przez filtr, który zatrzymywał bakterie. To odkrycie zrewolucjonizowało nasze podejście do chorób zakaźnych i otworzyło drzwi do badań nad wirusami.
W ciągu następnych lat, badania nad wirusami przyczyniły się do rozwoju nowych metod leczenia i szczepionek, które uratowały miliony istnień ludzkich. W artykule przyjrzymy się kluczowym datom i wydarzeniom związanym z odkryciem wirusów, a także ich znaczeniu dla współczesnej nauki i medycyny.
Kluczowe informacje:- Pierwsze odkrycie wirusów miało miejsce w 1892 roku przez Dmitriego Iwanowskiego.
- Iwanowski udowodnił, że wirusy mogą przenikać przez filtry, które zatrzymują bakterie.
- Odkrycie to zrewolucjonizowało badania nad chorobami zakaźnymi.
- Wyniki badań nad wirusami przyczyniły się do rozwoju szczepionek i terapii.
- Badania nad wirusami mają kluczowe znaczenie dla zrozumienia chorób wirusowych i ich leczenia.
Odkrycie wirusów: Kluczowe daty i wydarzenia w historii
Pierwsze odkrycie wirusów miało miejsce w 1892 roku, kiedy Dmitri Iwanowski wykazał, że czynnik zakaźny odpowiedzialny za chorobę mozaikową tytoniu potrafił przejść przez filtr, który zatrzymywał bakterie. To odkrycie otworzyło nowe możliwości badawcze i zrewolucjonizowało nasze rozumienie chorób zakaźnych. Od tamtej pory wiele kluczowych dat i wydarzeń ukształtowało dziedzinę wirusologii.
W ciągu XX wieku naukowcy dokonali wielu przełomowych odkryć dotyczących wirusów, co doprowadziło do rozwoju nowoczesnych metod diagnostycznych i terapeutycznych. Na przykład, w latach 30. XX wieku, odkryto wirusy zwierzęce, a w latach 50. XX wieku zidentyfikowano wirusy ludzkie. Te wydarzenia były fundamentalne dla zrozumienia wirusów i ich wpływu na zdrowie publiczne.
Jak przebiegała historia odkrycia wirusów i ich badania
Historia odkrycia wirusów jest długa i złożona. Początkowo, badania nad mikroorganizmami koncentrowały się głównie na bakteriach. Dopiero w XIX wieku, po odkryciach Iwanowskiego, zaczęto dostrzegać, że istnieją także inne patogeny, które są znacznie mniejsze od bakterii. W miarę postępu technologicznego, rozwijały się także metody badawcze, takie jak mikroskopia elektronowa, co pozwoliło na dokładniejsze badania wirusów.W miarę jak nauka ewoluowała, zaczęto klasyfikować wirusy według ich struktury i sposobu działania. Odkrycia te były kluczowe dla zrozumienia, jak wirusy wpływają na organizmy gospodarzy oraz jak można je zwalczać. Właśnie te postępy w badaniach nad wirusami stanowią fundament współczesnej wirusologii.
Kim byli pionierzy w odkrywaniu wirusów i ich znaczenie
Pionierzy w odkrywaniu wirusów odegrali kluczową rolę w rozwoju wirusologii. Dmitri Iwanowski jest jednym z najbardziej znanych naukowców, który przyczynił się do zrozumienia wirusów. Jego badania nad chorobą mozaikową tytoniu w 1892 roku ujawniły, że czynnik zakaźny potrafi przechodzić przez filtry, które zatrzymują bakterie. To odkrycie otworzyło nowe horyzonty dla badań nad wirusami i zapoczątkowało nową erę w biologii.
Innym istotnym pionierem był Wendell Meredith Stanley, który w latach 30. XX wieku wyizolował wirusa tytoniu i odkrył jego budowę chemiczną. Jego prace przyczyniły się do zrozumienia struktury wirusów i ich interakcji z komórkami gospodarza. Dzięki tym badaniom, wirusologia zyskała solidne podstawy naukowe, co miało ogromne znaczenie dla rozwoju medycyny i biologii molekularnej.
Rola Dmitriego Iwanowskiego w odkryciu wirusów
Dmitri Iwanowski jest uznawany za pioniera w badaniach nad wirusami. Jego kluczowe eksperymenty, przeprowadzone w 1892 roku, polegały na badaniu czynnika zakaźnego choroby mozaikowej tytoniu. Iwanowski odkrył, że ten czynnik potrafił przejść przez filtr, który zatrzymywał bakterie, co sugerowało, że istnieją organizmy mniejsze od bakterii. To odkrycie zmieniło dotychczasowe rozumienie patogenów i otworzyło nowe kierunki badań w biologii.
W swoich badaniach Iwanowski zastosował techniki filtracji, które pozwoliły mu na oddzielenie wirusa od innych mikroorganizmów. Jego prace przyczyniły się do stworzenia podstaw dla nowoczesnej wirusologii i zainspirowały wielu naukowców do dalszego badania wirusów. Dzięki jego odkryciom, wirusy zaczęły być postrzegane jako osobna kategoria patogenów, co miało ogromne znaczenie dla rozwoju medycyny oraz metod leczenia chorób wirusowych.
Jak eksperymenty Iwanowskiego zmieniły naukę o wirusach
Eksperymenty Iwanowskiego wprowadziły nowe metody badawcze do nauki o wirusach. Jego kluczowym osiągnięciem była filtracja, która pozwoliła na oddzielenie wirusów od bakterii. Dzięki temu naukowcy zaczęli dostrzegać, że wirusy mają zupełnie inną strukturę i sposób działania niż inne mikroorganizmy. Iwanowski udowodnił, że wirusy mogą być przenoszone przez rośliny, co otworzyło drogę do dalszych badań nad ich rolą w ekosystemach oraz w chorobach roślin i zwierząt.
Wpływ odkrycia Iwanowskiego na późniejsze badania wirusów
Odkrycia dokonane przez Dmitriego Iwanowskiego miały ogromny wpływ na rozwój badań nad wirusami. Jego prace w latach 90. XIX wieku zainicjowały nową erę w wirusologii, prowadząc do dalszych badań nad wirusami roślinnymi i zwierzęcymi. Iwanowski udowodnił, że istnieją patogeny mniejsze od bakterii, co skłoniło naukowców do poszukiwania nowych metod ich identyfikacji i klasyfikacji. Jego odkrycia stały się fundamentem dla przyszłych badań, które doprowadziły do zrozumienia mechanizmów działania wirusów oraz ich interakcji z organizmami gospodarzy.
W miarę jak wirusologia się rozwijała, kolejne pokolenia naukowców korzystały z metodologii opracowanej przez Iwanowskiego. Jego prace przyczyniły się do powstania nowoczesnych technik badawczych, takich jak mikroskopia elektronowa, która umożliwiła bezpośrednią obserwację wirusów. Dzięki temu zrozumienie wirusów, ich struktury oraz sposobów działania stało się kluczowe dla rozwoju terapii i szczepionek, które ratują życie milionów ludzi na całym świecie.
Czytaj więcej: Kiedy odkryć magnolie, aby uniknąć ich uszkodzenia po zimie?
Znaczenie odkrycia wirusów dla współczesnej nauki i medycyny

Odkrycie wirusów miało ogromne znaczenie dla współczesnej nauki i medycyny. Dzięki badaniom nad wirusami zrozumiano mechanizmy ich działania i wpływ na zdrowie ludzi. Odkrycia te doprowadziły do rozwoju nowoczesnych metod diagnostycznych, które umożliwiają szybkie i skuteczne wykrywanie chorób wirusowych. Wzrost wiedzy na temat wirusów pozwolił także na opracowanie skutecznych terapii i szczepionek, które są kluczowe w walce z epidemiami i pandemią.
Współczesna medycyna korzysta z osiągnięć wirusologii w wielu dziedzinach, od onkologii po immunologię. Odkrycie wirusów przyczyniło się do zrozumienia, w jaki sposób niektóre wirusy mogą prowadzić do nowotworów, co otworzyło nowe możliwości w terapii nowotworowej. Ponadto, dzięki badaniom nad wirusami, naukowcy są w stanie opracować szczepionki, które chronią przed groźnymi chorobami, takimi jak grypa, wirusowe zapalenie wątroby czy COVID-19.
- Szczepionka przeciwko wirusowi grypy - corocznie aktualizowana, aby odpowiadać na zmieniające się szczepy wirusa.
- Szczepionka przeciwko wirusowi HPV - zapobiega nowotworom szyjki macicy i innym chorobom związanym z wirusem.
- Szczepionka przeciwko wirusowi SARS-CoV-2 - kluczowa w walce z pandemią COVID-19.
Jak odkrycie wirusów wpłynęło na rozwój szczepionek i terapii
Odkrycie wirusów miało kluczowe znaczenie dla rozwoju nowoczesnych szczepionek i terapii. Przykładem jest sukces szczepionki przeciwko poliomyelitis, która została opracowana w latach 50. XX wieku przez Jonas Salk. Dzięki zrozumieniu mechanizmów działania wirusa polio, naukowcy byli w stanie stworzyć skuteczną szczepionkę, która zredukowała przypadki tej groźnej choroby o 99%. Podobnie, szczepionki przeciwko wirusowi grypy są corocznie aktualizowane, aby odpowiadać na zmieniające się szczepy wirusa, co jest możliwe dzięki badaniom nad wirusami.
Innym ważnym przykładem jest sukces szczepionki przeciwko wirusowi HPV, która pomaga w zapobieganiu nowotworom szyjki macicy. Odkrycia dotyczące wirusów umożliwiły także rozwój terapii przeciwwirusowych, takich jak leki stosowane w leczeniu HIV, które znacząco poprawiły jakość życia osób zakażonych. Dzięki badaniom nad wirusami, naukowcy są w stanie stale rozwijać nowe terapie i szczepionki, co ma ogromne znaczenie dla zdrowia publicznego.
Wpływ na zrozumienie chorób wirusowych i ich leczenie
Odkrycie wirusów znacząco wpłynęło na nasze rozumienie chorób wirusowych. Dzięki badaniom nad wirusami, takich jak wirus HIV i wirus grypy, naukowcy zyskali wgląd w mechanizmy zakażeń wirusowych oraz ich wpływ na organizm człowieka. Zrozumienie cyklu życiowego wirusów pozwoliło na opracowanie skutecznych strategii leczenia i zapobiegania chorobom, co jest kluczowe w walce z epidemiami. Ponadto, badania te przyczyniły się do rozwoju nowoczesnych metod diagnostycznych, które umożliwiają szybkie wykrywanie chorób wirusowych i ich skuteczne leczenie.
Jak przyszłość badań nad wirusami może zmienić medycynę
Przyszłość badań nad wirusami otwiera nowe możliwości w dziedzinie medycyny, które mogą zrewolucjonizować sposób, w jaki podchodzimy do leczenia chorób zakaźnych. Dzięki zastosowaniu technologii CRISPR i inżynierii genetycznej, naukowcy mogą nie tylko opracowywać nowe szczepionki, ale także modyfikować wirusy, aby działały jako nośniki terapeutyczne. Przykładem jest wykorzystanie wirusów do dostarczania leków bezpośrednio do komórek nowotworowych, co może zwiększyć skuteczność terapii i zredukować skutki uboczne.
W miarę jak badania nad wirusami będą się rozwijać, coraz większą rolę odegrają także technologie sztucznej inteligencji w analizie danych wirusologicznych. AI może pomóc w przewidywaniu, jak wirusy mutują i jakie strategie leczenia będą najbardziej skuteczne. To podejście może prowadzić do szybszego opracowywania szczepionek i terapii, co jest niezbędne w obliczu globalnych zagrożeń zdrowotnych, takich jak pandemie. W ten sposób, przyszłość badań nad wirusami nie tylko wzbogaci naszą wiedzę, ale także przyniesie realne korzyści dla zdrowia publicznego.